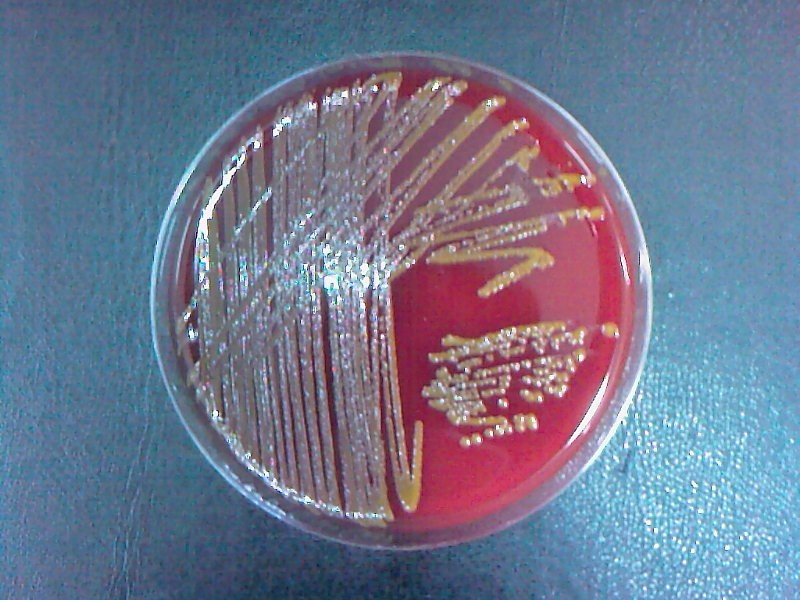
Alcaligenes faecalis биохимические свойства. Alcaligenes faecalis. Alcaligenes на производстве. Enterococcus faecalis на среде. Alcaligenes faecalis.

Alcaligenes faecalis. Ацинетобактер рост на средах. Рост alcaligenes faecalis на бульоне. Алкалигенес под микроскопом по граму. Alcaligenes на производстве.
Alcaligenes spp что это. Шигелла дизентерийная на среде плоскирева. Alcaligenes faecalis. Alcaligenes под микроскопом. Среда гиса микробиология.
Энтерококки на кровяном агаре. Alcaligenes faecalis. Alcaligenes eutrophus. Барофильные бактерии. Alcaligenes под микроскопом.
Окраска по лейфсону. Pantoea agglomerans. Энтерококк агар. Ахромобактер. Сальмонелла шигелла агар.
Барофильные микроорганизмы. Acinetobacter baumannii микробиология. Рост alcaligenes faecalis на бульоне. Алкалигенес микробиология. Acinetobacter микроскопия.
Enterococcus faecalis на кровяном агаре. Alcaligenes под микроскопом. Алкалигенес микробиология. Alcaligenes spp что это. Алкалигенес микробиология.
Alcaligenes eutrophus. Alcaligenes faecalis. Achromobacter колонии. Лактобациллы бактерии. Alcaligenes faecalis.
Alcaligenes faecalis. Alcaligenes eutrophus. Str. Alcaligenes spp что это. Achromobacter колонии.
Рост alcaligenes faecalis на бульоне. Aeromonas hydrophila. Alcaligenes faecalis. Alcaligenes eutrophus. Аэромоноз микроскопия.
Alcaligenes faecalis. Alcaligenes faecalis. Стафилококк фекалис. Alcaligenes faecalis. Alcaligenes под микроскопом.
Aeromonas salmonicida микроскопия. Alcaligenes под микроскопом. Alcaligenes faecalis. Shigella dysenteriae микробиология. Alcaligenes faecalis.
Алкалигенес микробиология. Alcaligenes faecalis. Alcaligenes spp что это. Enterococcus faecalis на среде. Вкпм штамм enterococcus faecalis.
Enterococcus faecalis на кровяном агаре. Алкалигенес микробиология. Aeromonas salmonicida микроскопия. Alcaligenes faecalis. Alcaligenes faecalis.
Alcaligenes eutrophus. Alcaligenes faecalis. Alcaligenes под микроскопом. Achromobacter колонии. Alcaligenes faecalis.
Alcaligenes под микроскопом. Рост alcaligenes faecalis на бульоне. Kocuria rhizophilaмфото. Alcaligenes faecalis. Aeromonas hydrophila микробиология.
Aeromonas hydrophila микробиология. Cellulomonas. Alcaligenes faecalis. Faecalis микроскопия. Alcaligenes под микроскопом по граму.
Alcaligenes faecalis биохимические свойства. Alcaligenes faecalis. Alcaligenes на производстве. Enterococcus faecalis на среде. Alcaligenes faecalis.
Alcaligenes eutrophus. Сальмонелла шигелла агар. Alcaligenes faecalis. Alcaligenes faecalis. Acinetobacter микроскопия.
Энтерококки на кровяном агаре. Alcaligenes faecalis. Enterococcus faecalis на среде. Shigella dysenteriae микробиология. Alcaligenes под микроскопом.
Alcaligenes faecalis. Alcaligenes faecalis. Alcaligenes eutrophus. Str. Enterococcus faecalis на кровяном агаре.